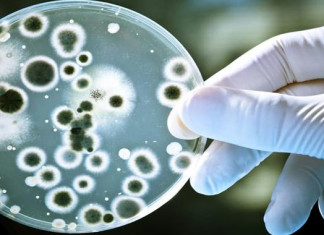

Proteína de la Malaria muestra potencial como tratamiento para el cáncer
Las mujeres embarazadas son particularmente vulnerables a lo parásito de la malaria, ya que produce una proteína que se une fácilmente a una molécula...
Gen podría tener la clave para tratar la enfermedad de Parkinson
Los investigadores del King´s College de Londres han identificado un nuevo gen relacionado con la función de los nervios, lo que podría proporcionar un...
Dolor abdominal crónico: cuando los intestinos y el cerebro están fuera...
Los trastornos gastrointestinales a menudo están vinculados a disfunciones psicológicas y pueden explicarse por un mal funcionamiento de la comunicación entre los intestinos y...
Fertilización in vitro: prueba de ADN novel ampliaría las tasas de...
En los EE.UU., la mayoría de las mujeres sometidas a fertilización in vitro tienen una tasa de éxito de 20 a 35%. Ahora, los...
Nuevas directrices para la edad de detección del cáncer de mama
Las mujeres deben tener la oportunidad de comenzar una evaluación anual para el cáncer de mama a partir de los 40 años y también...
Transfusión de sangre almacenada es «segura» después de una cirugía cardíaca
Durante las cirugías mayores, los pacientes, a menudo, necesitan transfusiones de glóbulos rojos para reemplazar la sangre que han perdido. Sin embargo, la cuestión...
Las «siestas» ayudan a la memoria y al impulso de aprendizaje
Un nuevo estudio revela que una siesta durante el día puede aumentar la consolidación del aprendizaje que está vinculado a las recompensas. Usando imágenes...
Grumos de proteínas son el alvo para nuevos tratamientos de Parkinson
Un nuevo estudio aporta nuevas ideas en un posible método molecular para la reducción de los cuerpos de Lewy - cúmulos de proteínas que...
El parto prematuro puede debilitar las conexiones del cerebro de los...
Es bien conocido que los bebés nacidos prematuramente tienen un mayor riesgo de discapacidades en el desarrollo. Ahora, una nueva investigación sugiere que esto...
Banda gástrica: ¿Cuál es la clave para que funcione como tratamiento...
La banda gástrica es un tratamiento para la obesidad muy popular y ampliamente utilizado y reconocido en países como EEUU, Australia, Francia, etc... con...
Las personas en estado vegetativo pueden ser capaces de responder
Las terapias que ayuden a la gente a comunicarse, a pesar de que estén en un estado vegetativo, podrían estar disponibles dentro de unos...
Revelado el papel clave que desempeñan las bacterias intestinales en defensa...
Apuntase otra razón por la cual sus bacterias intestinales son tan importantes para su salud - y por qué podrían ser la clave para...